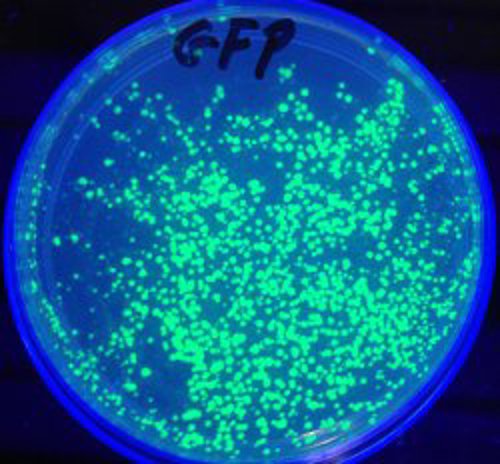

What part of the jellyfish does the GFP gene come from?
February 28, 2014

- Related Topics:
- Genetic engineering,
- Biotechnology,
- Bioinformatics
A visitor from the Tech Museum asks:
"In the wet lab of the Genetics exhibit at The Tech Museum, I added jellyfish DNA to a bacteria to make it glow. What part of the jellyfish did the samples come from? The bell, tentacles, etc."
The original DNA for the Wet Lab* came from pretty much all the different parts of a jellyfish. This is even though only a few parts of the jellyfish actually glow.
We can get the gene from any part of the jellyfish because almost every one of its cells has the same set of DNA. The same is true for most every beast including us.
The reason only some of a jellyfish’s cells glow has to do with how each kind of cell uses the genes it has. The cells that glow turn on the green fluorescent protein (GFP) gene naturally found in jellyfish DNA. The non-glowing cells keep this gene off.

The same kind of thing explains why our hearts aren’t hairy or why our feet can’t see. All the instructions for every part of us are in our DNA but different kinds of cells use only the parts they need.
It is like using a cookbook. You’d never make every recipe in the cookbook every time. If you want to make chocolate chip cookies, you’d only use that recipe. Same thing with creatures like jellyfish and people.
Humans shouldn’t have all of their cells make everything in their cookbook. Who needs hairy eyeballs that make insulin and can digest milk? No, each cell uses its own set of genes.
As you can see, scientists didn’t need to focus on just the cells that glow to find the original gene. But those glowing cells can make finding the gene easier the first time.
Cloning the GFP Gene
Getting the GFP gene we use in the wetlab here at The Tech is easy nowadays. You can either buy it or get it from a lab somewhere. But getting it the first time was really hard to do.
The first step involved grinding up 10,000 or so jellyfish and getting the glow away from everything else in a jellyfish. This isn’t enough though. It isn't the GFP gene that glows. Instead, the gene has the instructions for making a protein that glows. So the scientists were really purifying the GFP protein away from all the other thousands of proteins in a jellyfish.

The next step was to figure out a little something about their purified GFP protein. What they needed was just a bit of its amino acid sequence.
Proteins are really just a long string of twenty or so different amino acids stuck together, one after the other. Each protein has a unique string of them.
Once scientists were able to figure out a short string of these amino acids from GFP, they used that information to find the GFP gene itself. They were able to do this because the language genes use is simple enough that you can figure out what a gene might look like from the order of amino acids in a protein.
Simple Language, Complex Beasts
Basically what scientists want to do is use the short string of amino acids from a protein to figure out what part of that protein’s gene might look like. You can think of this as finding a sentence from a random book and then searching a database to find the book it came from. In this analogy, the sentence is the snippet of the gene we are able to figure out from the protein and the book is the gene.
We can go from protein to gene because the instructions in a gene are written in such a simple language. The genetic code has just four letters — the A’s, T’s, G’s and C’s of DNA — and all the words are three letters long. Since there are four letters in this alphabet, this means there are only 64 words in the whole language.
Most of these three letter words, called codons, stand for an amino acid. Sort of like certain strings of letters refer to something. B-A-L-L stands for a ball, D-O-G for dog and so on.
Here’s a full chart showing how DNA letters correspond to amino acids:

Imagine the following very short bit of protein:
Met-Lys-Cys-Tyr-Asp
It is only five amino acids long. Each amino acid is abbreviated with a three letter code.
Since each codon stands for an amino acid, in theory we should be able to go backwards from the amino acids to the DNA. Like if we have a picture of a ball, we can figure out B-A-L-L.
The first amino acid in our bit of protein is Met or methionine. The codon for Met is ATG so the first part of this part of the gene is ATG.
The next amino acid Lys (or lysine) is trickier. This is because lysine, like many other amino acids, actually has more than one codon. It is like dog and canine meaning the same thing.
There are two codons for lysine, AAA and AAG. This means our gene sequence has expanded to either ATGAAA or ATGAAG.
Scientists keep doing this until they get something at least around 20 letters long. Since there is usually more than one codon for each amino acid, they make every possible bit of DNA that might code for that string of amino acids. They then use that DNA to fish out the gene from an organism’s DNA.
How Glowing Cells Could Help
Now to get back to your question, we are now at the point where the bit of the jellyfish that glows might help. We can use these cells to simplify our search for the gene.
It turns out that a whole lot of a beast’s DNA isn’t genes. For example, only something like 2% of human DNA is genes. So ideally scientists would like to get rid of all that extra stuff and focus on just the genes. In our book analogy, we are getting rid of all the nonfiction and focusing on just the works of fiction.
To pick out only genes, scientists take advantage of the fact that when a gene is read, it is first copied into RNA. So scientists take this RNA, turn it into DNA and then use this “cDNA library” to find their gene. They have peeled away all the “junk” DNA leaving behind only the genes.
This is still an awful lot of DNA and how often your gene turns up in your library depends on how much of its RNA was originally in the organism. If the gene you’re interested in is only on in a few cells or at a low level in lots of cells, it may be pretty rare in the library. This is where focusing on just the cells where your gene is turned on can help.
Scientists can make finding the gene much simpler if they only use parts that read the gene they are interested in. When they do this, a higher percentage of the DNA they look at has their gene which means less searching. It is sort of like knowing that the sentence came from a Steinbeck novel and so you only look through his books.
Now given how tricky it might be to just get the glowing bits, my guess is they made their library from whole jellyfish. But this is something scientists definitely do with more complex animals. For example, if they are interested in a gene that is only on in the brain, they will often only look there.
So there you have it. Scientists didn’t need to pull the GFP gene from just the glowing parts of the jellyfish. Since every cell has the same DNA, they could use the whole animal.
*The Wet Lab exhibit was replaced in 2016 with Living Colors Lab. This newer exhibit has 3 colors that can mix and match to make a rainbow of possibilities:
- Green (“sfEmerald” DNA) is a lab-created descendant of GFP. It’s even brighter than the original!
- Red (“mCherry” DNA) originally comes from sea anemones. It was originally isolated the same way as this article describes for green.
- Blue (“mBlueberry” DNA) is a lab-created descendant of the red anemone DNA.
Read More:
- Livescience: How a jellyfish protein transformed science
- Connecticut College: More about the discovery and isolation of GFP
- Addgene: A history of fluorescent proteins

Author: Dr. Barry Starr
Barry served as The Tech Geneticist from 2002-2018. He founded Ask-a-Geneticist, answered thousands of questions submitted by people from all around the world, and oversaw and edited all articles published during his tenure. AAG is part of the Stanford at The Tech program, which brings Stanford scientists to The Tech to answer questions for this site, as well as to run science activities with visitors at The Tech Interactive in downtown San Jose.
 Skip Navigation
Skip Navigation
